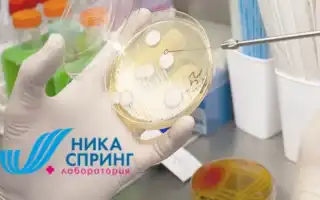
Определение кандидоза путем сдачи анализа мочи на лейкоциты в медицинских учреждениях

Признаки и причины возникновения кандидоза
Вагинальный кандидоз — это одно из самых распространенных заболеваний, которое в основном затрагивает женщин, в то время как у мужчин оно проявляется гораздо реже. Стоит отметить, что случаи кандидоза у обоих полов имеют схожие проявления, однако мужчины значительно реже обращаются к врачам, чем женщины к гинекологам.
Основными признаками вагинального кандидоза являются зуд и жжение во влагалище, а также выделения творожистой консистенции из области промежности. Эти симптомы могут усиливаться после душа, полового акта или во время сна. Женщины, заметившие подобные проявления, обычно обращаются к врачу, который ставит диагноз и назначает необходимое лечение. Если не обратиться за медицинской помощью вовремя и заниматься самолечением, это может привести к вовлечению в патологический процесс органов мочевыводящей системы.
Причины возникновения кандидоза могут быть разнообразными, однако наиболее распространенной считается ослабление иммунной системы. В организме человека присутствует как полезная, так и патогенная флора. Грибок Кандида не является исключением. При нормальной работе иммунной системы грибок находится в неактивном состоянии. Однако при ослаблении защитных функций организма количество патогенных микроорганизмов начинает превышать количество полезных бактерий, что приводит к активному размножению грибка Кандида и, соответственно, к развитию заболевания. На возникновение кандидоза также влияют следующие факторы:
- Заболевания половой системы;
- Эндокринные расстройства;
- Хронические инфекции;
- Нарушения обмена веществ;
- Беременность, когда женский организм становится более уязвимым.
Предотвратить появление молочницы довольно сложно, поэтому при первых признаках заболевания следует незамедлительно начать лечение. Игнорирование проблемы может привести к серьезным осложнениям в области половой системы, включая бесплодие.
Врачи отмечают, что анализ мочи на лейкоциты может служить важным индикатором наличия воспалительных процессов в организме, однако его использование для диагностики кандидоза требует осторожности. Повышенное количество лейкоцитов в моче может свидетельствовать о различных инфекциях, включая бактериальные и грибковые. Тем не менее, кандидоз, вызванный грибами рода Candida, чаще всего проявляется в других формах, таких как молочница, и его диагностика требует более специфичных методов. Врачи подчеркивают, что для точного определения кандидоза необходимо учитывать клинические симптомы и проводить дополнительные исследования, такие как анализ мазка или культуральное исследование. Таким образом, анализ мочи на лейкоциты может быть полезен в комплексной оценке состояния пациента, но не является единственным и окончательным методом диагностики кандидоза.

Мазок на флору при молочнице
Для диагностики кандидоза врач учитывает не только клинические проявления заболевания, но и результаты соответствующих анализов. Одним из наиболее популярных методов для выявления кандидоза является взятие мазка на флору. Эффективность этого подхода достигает 95%. При молочнице наблюдается увеличение количества лейкоцитов в мазке, что указывает на активацию защитных механизмов организма в борьбе с патогенными микроорганизмами.
Отсутствие явных симптомов кандидоза не всегда означает, что женщина свободна от заболевания. Сдача мазка на флору предоставляет гинекологу точные данные о состоянии репродуктивной системы. Перед тем как сдать мазок, женщине следует выполнить несколько рекомендаций по подготовке:
- За несколько дней до анализа следует воздержаться от половых контактов;
- Не проводить спринцевания за 2 дня до визита к врачу;
- Прекратить использование свечей, таблеток и кремов;
- За несколько часов до анализа не мочиться;
- Подмываться только водой без мыла и других химических средств.
Рекомендуется обращаться к специалисту сразу после окончания менструации или перед их началом. Для забора мазка из уретры используется ложка Фолькмана, из влагалища – стерильный тампон, а из шейки матки – шпатель Эйра. Цель анализа заключается в подсчете количества различных микроорганизмов и лейкоцитов. Лейкоциты в мазке при молочнице выявляются с помощью специальных красителей.
Результаты анализов содержат информацию о количестве лейкоцитов. Нормальные значения зависят от места забора материала. Для различных участков тела нормальными считаются следующие показатели:
- В моче – от 0 до 10;
- Во влагалище – от 0 до 15;
- В цервикальном канале – от 0 до 30;
Во время беременности количество лейкоцитов может увеличиваться до 15-20. Кроме того, в анализе могут быть обнаружены следующие компоненты:
- Слизь;
- Участки плоского эпителия;
- Лактобациллы;
- Лептотрикс;
- Грамотрицательные бактерии.
В норме грибки рода Кандида могут не выявляться в анализах, однако при их увеличении врач ставит диагноз молочница.
| Показатель | Норма | Интерпретация при кандидозе |
|---|---|---|
| Количество лейкоцитов в моче | До 5 в поле зрения | Повышенное количество (более 5 в поле зрения) может указывать на воспаление мочевыводящих путей, в том числе вызванное грибками рода Candida. |
| Наличие мицелия грибов | Отсутствует | Обнаружение нитей мицелия грибов рода Candida подтверждает наличие кандидоза мочевыводящих путей. |
| Наличие дрожжевых клеток | Отсутствует | Обнаружение дрожжевых клеток (почкование) в большом количестве может свидетельствовать о кандидозе. |
О чем говорит повышенное число лейкоцитов в моче
Для диагностики кандидоза врач может направить пациента на анализ мочи. При наличии воспалительных процессов наблюдается повышенное содержание лейкоцитов. Уровень лейкоцитов в моче при молочнице также увеличивается, и, следовательно, чем острее заболевание, тем выше их количество.
Повышенное количество лейкоцитов в моче при молочнице свидетельствует о том, что организм активно борется с инфекцией. Число белых кровяных клеток увеличивается в крови, и через кровоток они распространяются по всему организму. Эти клетки проникают в слизистые оболочки различных органов, а также в мочу.
Высокий уровень лейкоцитов в крови представляет серьезную угрозу для беременных женщин. Это связано с тем, что у матери и ребенка общий кровоток, что увеличивает риск внутриутробного инфицирования плода. В период беременности женщины должны регулярно проходить анализы на флору. При обнаружении повышенного количества лейкоцитов врач назначает необходимое лечение.
Отсутствие явных симптомов, но наличие в моче высокого уровня лейкоцитов может указывать на развитие кандидоза у женщины. Неприсутствие дискомфорта вовсе не означает, что женщина не заражена грибком Candida. Этот микроорганизм может находиться в организме длительное время, не проявляя себя.
Многие люди, столкнувшиеся с проблемами, связанными с кандидозом, отмечают, что анализ мочи на лейкоциты стал для них важным шагом в диагностике. Лейкоциты, как известно, являются маркерами воспаления, и их повышенное количество может указывать на наличие инфекции, в том числе и грибковой. Некоторые пациенты делятся, что этот анализ помог им быстрее выявить проблему и начать лечение. Однако не все уверены в его точности, так как лейкоциты могут повышаться и при других заболеваниях. Важно, чтобы результаты анализов интерпретировались врачом в контексте других симптомов и исследований. Многие рекомендуют не игнорировать консультацию специалиста, чтобы избежать неправильной самодиагностики и назначения лечения.

Какие заболевания приводят к повышению лейкоцитов в моче
Повышение уровня лейкоцитов в моче, связанное с кандидозом, не всегда является корректным. Высокие показатели могут указывать на наличие заболеваний в репродуктивной системе женщин. Основные причины увеличения количества лейкоцитов в моче включают:
- Воспалительные процессы в уретре, известные как уретрит;
- Воспаления придатков;
- Воспалительные изменения в шейке матки;
- Воспаление влагалища;
- Злокачественные опухоли;
- Дисбактериоз во влагалище и кишечнике;
- Инфекции половых органов.
При увеличении числа лейкоцитов в моче и мазке может потребоваться проведение бактериологического исследования. Цель этого анализа — осуществить посев на питательную среду. С помощью бакпосева можно определить видовую или родовую принадлежность грибков рода Candida. Этот метод также позволяет оценить чувствительность грибка к противогрибковым препаратам.
Если есть подозрения на кандидоз, но отсутствуют характерные симптомы, может быть принято решение о проведении кольпоскопии. Однако стоит отметить, что данный метод не позволяет точно определить возбудителя инфекции.
Терапевтическое лечение заболевания
При диагностике заболевания «молочница» врач применяет комплексный подход к терапии. Основные этапы такого лечения включают:
- Назначение средств, способствующих восстановлению защитных функций организма.
- Использование препаратов для устранения местных симптомов заболевания. В этом случае могут быть рекомендованы спринцевания, вагинальные свечи, таблетки и мази.
- Терапия кандидоза с помощью медикаментов.
- Применение средств народной медицины. Это особенно актуально во время беременности и грудного вскармливания, когда химические препараты могут оказать негативное воздействие на плод.
Лечение направлено на уничтожение грибка Кандида. Полностью избавиться от грибка в организме практически невозможно, поэтому важно начинать борьбу с недугом при первых признаках его появления. Если назначенные врачом препараты не дают ожидаемого результата, специалист должен скорректировать схему лечения.

Профилактические мероприятия
Чтобы избежать возникновения молочницы, необходимо принимать меры предосторожности. Многие люди не осознают, что существуют эффективные способы профилактики, и в итоге становятся жертвами этого неприятного заболевания. К основным рекомендациям по предотвращению кандидоза можно отнести:
- Не принимать антибиотики без назначения врача;
- Регулярно укреплять иммунную систему;
- Своевременно выявлять и лечить инфекции половой системы;
- Использовать средства контрацепции во время половых актов;
- Соблюдать сбалансированное питание, не исключая из рациона важные углеводы;
- Минимизировать стрессовые ситуации и переживания;
- Увеличивать количество полезных бактерий в организме с помощью кисломолочных продуктов;
- Предпочитать натуральное белье вместо синтетического;
- Для интимной гигиены использовать только специальные средства без добавок и красителей.
Если женщина, страдающая кандидозом, имеет постоянного полового партнера, ему также следует пройти курс лечения. В большинстве случаев мужчины могут быть носителями молочницы, даже не подозревая об этом.
Вопрос-ответ
Можно ли определить кандидоз по анализу мочи?
Выявление ДНК Candida albicans в моче используется для подтверждения инфицированности при наличии характерных клинических признаков инфекции в мочевыделительной системе, для оценки эффективности противогрибковой терапии при кандидозе.
Какие лейкоциты при кандидозе?
Мазок на флору, в котором при кандидозе значительно повышается содержание лейкоцитов выше 20 и обнаруживаются споры или мицелий грибов.
Может ли кандида вызывать лейкоцитоз?
Системный кандидоз (острый диссеминированный кандидоз) — это инфекция крови или других обычно стерильных органов (например, плевральной и брюшной жидкости), вызванная видами рода Candida, обычно сопровождающаяся лихорадкой, гипотонией и/или лейкоцитозом.
Какой самый точный анализ на кандидоз?
ПЦР-метод является одним из самых точных и чувствительных для диагностики грибковых инфекций. Он не только выявляет Candida albicans, но и позволяет дифференцировать этот вид от других представителей рода Candida.
Советы
СОВЕТ №1
Перед сдачей анализа мочи на лейкоциты, убедитесь, что вы правильно подготовились: избегайте употребления алкоголя, острых и раздражающих продуктов, а также не принимайте антибиотики за несколько дней до анализа, чтобы результаты были максимально точными.
СОВЕТ №2
Соблюдайте правила сбора мочи: используйте стерильный контейнер, и обязательно собирайте среднюю порцию мочи, чтобы избежать попадания в анализ загрязняющих веществ из уретры.
СОВЕТ №3
Обсудите с врачом результаты анализа и возможные дальнейшие шаги. Если уровень лейкоцитов повышен, это может указывать на инфекцию, и важно не откладывать лечение.
СОВЕТ №4
Следите за своим состоянием и обращайте внимание на симптомы кандидоза, такие как зуд, жжение или необычные выделения. Раннее обращение к врачу поможет избежать осложнений и ускорить процесс выздоровления.